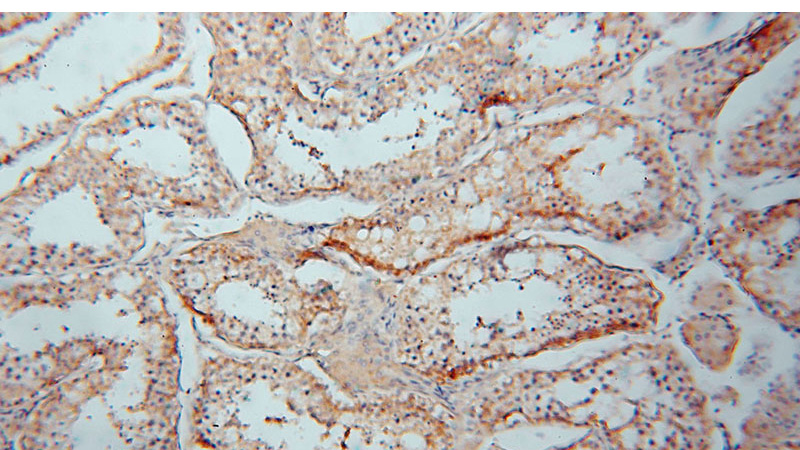
Immunohistochemical of paraffin-embedded human testis using Catalog No:109415(CMIP antibody) at dilution of 1:50 (under 10x lens)

-
Product Name
CMIP antibody
- Documents
-
Description
CMIP Rabbit Polyclonal antibody. Positive IHC detected in human testis tissue, human brain tissue, human heart tissue, human kidney tissue, human liver tissue, human lung tissue, human ovary tissue, human placenta tissue. Positive WB detected in Raji cells, K-562 cells. Positive IP detected in Raji cells. Observed molecular weight by Western-blot: 75 kDa
-
Tested applications
ELISA, WB, IHC, IP
-
Species reactivity
Human,Mouse,Rat; other species not tested.
-
Alternative names
c Maf inducing protein antibody; c Mip antibody; CMIP antibody; KIAA1694 antibody; Tc Mip antibody; TCMIP antibody
-
Isotype
Rabbit IgG
-
Preparation
This antibody was obtained by immunization of CMIP recombinant protein (Accession Number: BC038113). Purification method: Antigen affinity purified.
-
Clonality
Polyclonal
-
Formulation
PBS with 0.1% sodium azide and 50% glycerol pH 7.3.
-
Storage instructions
Store at -20℃. DO NOT ALIQUOT
-
Applications
Recommended Dilution:
WB: 1:200-1:2000
IP: 1:200-1:1000
IHC: 1:20-1:200
-
Validations

Raji cells were subjected to SDS PAGE followed by western blot with Catalog No:109415(CMIP antibody) at dilution of 1:400
Immunohistochemical of paraffin-embedded human testis using Catalog No:109415(CMIP antibody) at dilution of 1:50 (under 10x lens)

Immunohistochemical of paraffin-embedded human testis using Catalog No:109415(CMIP antibody) at dilution of 1:50 (under 40x lens)

IP Result of anti-CMIP (IP:Catalog No:109415, 4ug; Detection:Catalog No:109415 1:300) with Raji cells lysate 2000ug.
-
Background
The gene of CMIP was isolated from one patient of minimal change nephrotic syndrome. The gene encodes two isoforms: CMIP and truncated CMIP. The predicted CMIP and truncated CMIP proteins contain 739 and 679 amino acids and have calculated molecular masses of 85 and 75 kD, respectively. The two isoforms have different distribution and expression pattern.
-
References
- Yu L, Lin Q, Feng J. Inhibition of nephrin activation by c-mip through Csk-Cbp-Fyn axis plays a critical role in Angiotensin II-induced podocyte damage. Cellular signalling. 25(3):581-8. 2013.
- Liu Y, Su L, Lin Q, Han Y, You P, Fan Q. Induction of C-Mip by IL-17 Plays an Important Role in Adriamycin-Induced Podocyte Damage. Cellular physiology and biochemistry : international journal of experimental cellular physiology, biochemistry, and pharmacology. 36(4):1274-90. 2015.
Related Products / Services
Please note: All products are "FOR RESEARCH USE ONLY AND ARE NOT INTENDED FOR DIAGNOSTIC OR THERAPEUTIC USE"
